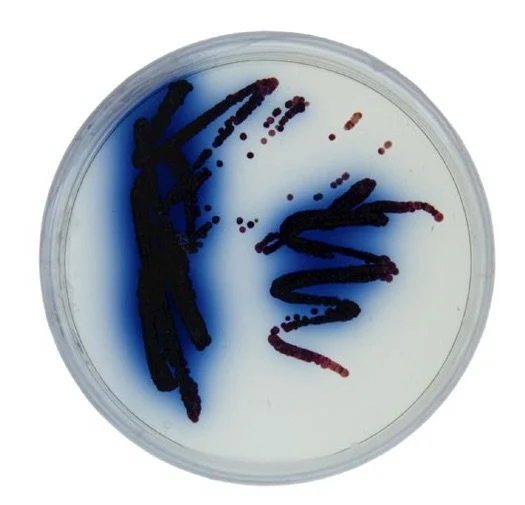

Ontology of Scent
Scent-driven architecture, emphasizing toolsets for design, VOC control, and the intangible
TEAM
Concept Design | Julia Brière
Laboratory | Hana Cvelbar + Julia Brière
Fabrication | Penn Ryan, Julia Brière + Hana Cvelbar
Computation | Satyam Gyanchandani
Photography by Julia Brière
ABOUT
This study centers on exploring scent integration in architecture, focusing on Saint Andrew’s Botanical Garden in Scotland. It aims to establish a methodological framework and toolset specifically tailored for scent-driven design applications. Understanding scent intricacies precedes leveraging its creative potential, highlighting the nascent stage of scent-related methodologies in parallel with conventional construction practices.
The project lays the groundwork for a comprehensive toolset enabling designers to grasp scent behavior and properties. Delving into Volatile Organic Compounds (VOCs), it categorizes them by origin, emphasizing their roles in scents, ecosystems, and potential health hazards indoors, necessitating stringent material design aligned with healthcare regulations. Recognizing the imperative of controlling VOC emissions from building materials, especially indoors, this underscores the need for refined design and manufacturing practices to address emission dynamics effectively.
01
Laboratory:
Bacterial + hydrogel exploration
BACTERIA
Streptomyces Coelicolor
The goal is to integrate S. coelicolor into architectural materials, creating a beneficial molecular atmosphere that influences human emotions or fosters a healthy environment that supports biodiversity.
This soil bacterium has a remarkable ability to emit odor molecules with a characteristic "earthy smell," produced by a compound called geosmin. In this study, S. coelicolor bacteria will be incorporated into the built environment as a scent-producing component.
HYDROGELS
Potential for novel design approaches
Hydrogel embedded in 3D printed structure
Hydrogels were chosen as the ideal material to host the bacteria due to their unique properties. These hydrophilic polymers do not dissolve in water but are capable of absorbing and retaining significant amounts of it, making them well-suited for supporting living organisms.
The fabrication process involved using a biocompatible compound that can absorb large quantities of water. A key feature of hydrogels is their ability to allow ions, such as calcium and salt ions, to move through their structure, eventually solidifying over time. Additionally, hydrogels are highly stretchable, a quality that was essential for achieving the weaving objectives of this project.
MATERIAL EXPLORATION
Optimizing hydrogel materiality for bacterial integration
The experiments include dehydration and hydration tests, biocompatibility assessments, extrusion trials, and other evaluations to thoroughly analyze the characteristics of the hydrogels.

CH-Na Alginate 3:4 0.5% acetic acid

CH-Na Alginate 4:7 0.5% acetic acid

CH-Na Alginate 4:7 0.2% acetic acid

Dried 4 days: CH-Na Alginate 3:4 0.5% acetic acid

Dried 7 days: CH-Na Alginate 3:4 0.5% acetic acid

Dried 8 weeks: CH-Na Alginate 3:4 0.5% acetic acid
Fabrication:
Weaving with hydrogels
02
FIBER EXSTRUSION
Developing fiber forms for weaving techniques
The goal of this phase was to create fibers suitable for weaving techniques, focusing on their flexibility and dynamic properties. Various fiber thicknesses were produced to determine the most effective form for fabrication. Fiber extrusion was initially performed manually and later through robotic fabrication.
The manual extrusion process, shown below, was not ideal as it resulted in irregular and non-homogeneous fibers. Subsequently, manual weaving was conducted on smaller-scale samples. This sample demonstrated better moisture retention compared to individual hydrogel fibers.






SCALING UP
Testing new methods + techniques
Manual hydrogel weaving was later performed on a bigger looms. Below loom of 15 cm by 15 cm was created.
S. COELICOLOR + HYDROGEL
Integrating bacteria into hydrogels
The purpose of embedding S. coelicolor was to release the odor compound geosmin, allowing scent intensity to vary with environmental and growth conditions. This integration enables design in the immaterial realm, engaging senses beyond sight to create a multi-sensory experience.
-

S. coelicolor in hydrogel weaved on 3D printed structure
-

-

03
Computation:
Voc,Cfd + vector fields
THE STRUCTURAL DESIGN
Enhancing the scent experience of microorganisms in urban landscapes
This area explores designing sensory spaces that use natural, biobased scents, guided by environmental data. The scent is generated by Streptomyces coelicolor bacteria, which thrive in natural environments. Because the scent produced by bacteria is intangible and lacks a standard design template, this research delves into advanced tools and workflows to address these challenges.
VOC simulation with multiple emitters dispersing through the interior of a vector field geometry
VOC simulation on vector geometry